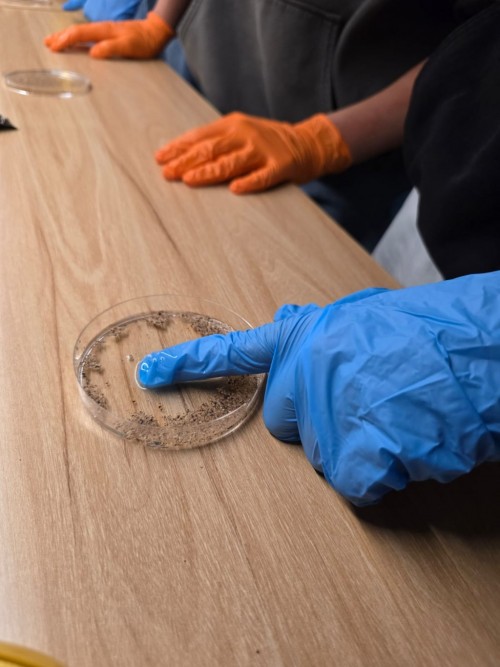
WhatsApp-Image-2025-12-04-at-11.14.52-5.jpg

- پویش
- جستجو
-
Advanced search
- Lights
- آپلود عکس
- ورود
- درباره
-
FA
- العربية
- Български
- Čeština
- Dansk
- Deutsch
- Ελληνικά
- English
- Español
- Eesti (Eesti)
- فارسی
- Suomi
- Français
- עברית
- Magyar
- Bahasa Indonesia
- Italiano
- 日本語
- 한국어
- Lietuvių (Lietuva)
- Norsk Bokmål
- Nederlands
- Polski
- Português (Brasil)
- Português
- Русский
- Slovenčina
- Српски
- Svenska
- ไทย
- Türkçe
- Українська
- Tiếng Việt
- 简体中文
- 繁體中文